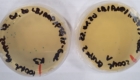

Herzlich willkommen
an der Gesamtschule Heiligenhaus
Herzlich Willkommen auf der Homepage der Städt. Gesamtschule Heiligenhaus!
An unserer Schule fühlen wir uns gleichermaßen der Bildung und Erziehung verpflichtet und haben das Ziel, junge Menschen individuell
zu fördern und optimal auf die Anforderungen ihrer (beruflichen) Zukunft vorzubereiten. Dabei vergeben wir alle Schulabschlüsse, vom „Ersten Schulabschluss“ bis zum zentralen Abitur. Wie wir das Lernen gestalten und die Kinder bzw. Jugendlichen auf ihrem Weg begleiten, dazu finden Sie Informationen hier auf unseren Seiten.
Gerne können Sie uns auch am Tag der offenen Tür am 06.12.25 von 10.00 – 13.00 Uhr persönlich kennen lernen und erleben.
Herzliche Grüße
Carmen Tiemann, Schulleiterin
Projekte zum Deutsch-Französischen Tag 2025
Anlässlich des Deutsch-Französischen Tages erarbeitete die Gesamtschule Heiligenhaus mit ihren Partnern aus Meaux, dem Lycée Henri Moissan und dem Collège Albert Camus, digitale Projekte zu der Frage, warum die deutsch-französischen Beziehungen gerade heute noch wichtig sind.
Abitur 2025
Herzlichen Glückwunsch!!
66 Schülerinnen und Schülern der Gesamtschule Heiligenhaus haben erfolgreich das Abitur bestanden. Eine Schülerin erreichte die Traumnote von 1,3. Weitere 13 Schülerinnen und Schüler haben ein Abitur mit einer 1 vor dem Komma.
Die Abiturientinnen und Abiturienten der Gesamtschule Heiligenhaus in alphabetischer Reihenfolge:
Ibrahim Alansari, Rozerin Arbac, Tim Alexander Arnold, Noah Bachmann, Jona Ben Balkan, Kay-Christin Beckmann, Lili Viktoria Bitto, Peter Bocken, Patricia Bongartz, Anastasia Bozidis Lopez, Lill Bullmann, Jessica Castro, Eleftherios Christoforidis, Jeric Doege, Lioba Floß, Anna Carlotta Grützner, Can Gündüz, Catharina Hahn, Simon Hansen, Tim Hartwig, Jakob Hinze, Melissa Hunke, Melina Jokiel, Alexander Jungblut, Marlon Oliver Karkutt, Rene Andre Klein, Franziska Anna Ilse Korinth, Meriam Kouakoua, Jonas Paul Kuczaty, Ricarda Kühn, Max Luca Leßmüller, Lara Marie Leßmüller, Ole Nellen, Joan Ockomm, Daniel Ohlhoff, Rosa Hevi Öztürk, Jacob Prisille, Lena-Marie Remmert, Lynn Richter, Justus Ruhnau, Julia Rzok, Nikola Sadura, Lilith Morgana Scherf
Preview unavailable
Katharina Schmid, Max Oliver Schreiner, Johannes Schuster, Sarah Marie Selbig, Noé Aurelio Sonsalla, Jannes Phil Spiegel, Noemie Stamm, Linus Stein, Eric Steinmeier, Mia Sophie Stepien, Nele Stock, Lucy Sarah Thomas, Emma Charlotte Thönes, Nina Maria Tuschen, Umut Fazli Ünal, Baran Üstebay, Jean Maurice van Drunick, Talha Vizel, Vuk Vuckovic, Fynn Malte Waindock, Celina Yasin, Melike Yenigün
Wir sind dann mal weg – mit Zeugnis in der Hand, Durchblick und Zukunft im Gepäck!“-10er Abschluss der Gesamtschule Heiligenhaus
Am 4.Juli 2025 haben unsere 10er gezeigt, dass sie nicht nur Prüfungen meistern, sondern auch feiern können! Mit einer Mischung aus guter Laune, ein paar sentimentalen Momenten und jeder Menge Witz wurde der Abschluss ordentlich zelebriert. Begleitet von Applaus, Erinnerungen und einem Hauch Wehmut klang der Abend bei einem gemütlichen Beisammensein aus. Wir gratulieren allen Absolventinnen und Absolventen herzlich und wünschen alles Gute für den weiteren Weg! Jetzt heißt es: Tschüss Schulalltag, hallo Zukunft! Wir sind stolz auf euch – bleibt so einzigartig, chaotisch und großartig wie ihr seid!
10a mit Herrn Livshits und Frau Uhlenbruck:
Niclas Albrecht, Lada Baksic, Hannah Bohsmann, Efe Dasdemir, Jannes Dellit, Merle Espey, Timon Ganswindt, Mia Gerks, Inass Houbar, Joudi Hares Raffi, Julia Hoffmann, Maxim Jungblut, Zara Kaymaz, Ela Koca, Evelin Koslov, Tiffany Krauss, Sophia Krüger, Shayan Mahmoudi, Malte Müller, Jannik Schmidt, Leonie Schwert, Nicolas Steinhauer, Anastasia Sverkos, Victor Vos, Bennet Waindock, Emely Wittig.
10b mit Frau Reiff und Herrn Wesselbaum:
Elias Adolphs, Derya Agilgat, Elias Beduhn, Maximiliam Braun, Erik Cuadari, Dustin Deeg, Filip Dorszewski, Linus Doveden, Lina Hartwig, Maurice herrmann, Noah Kamphausen, Sofia Klintsiari, Sophie Kußin, Meyra Lekesiz, Katarzyna Lipiec, Thorben Nellen, Luc Over, Armandas Saudargis, Tobias Schramm, Michel Schulz, Leonie Schrön, Lennard Strehl, Malik Toubaye, Lilly Vester, Leon Viehausen, Florian von Praun, Tamia Wallace, Tugce Yildiz.
Preview unavailable
10c mit Frau Nykyforuk und Herrn Dahm:
Lana Alahmad, Paul Bannscheidt, Alissa Bolt, Fiona Brakonier, Ela Cebi, Anis Djouhri, Ana Felderhoff, Smilla Grote, Zoe herrmann, Julius Janikulla, Len Kleinert, Lara Koyun, Lura Kucal, Jason Liesner, Jan Menkens, Charlotte Minihan, Marlena Müller, Tom Pörting, Julius Rohde, Ben Röskes, Finja Schatz, Chiara Scognamiglio, Lennard Sorns, Piet Thiemann, len Weith, Malin Wolff.
10d mit Frau Derbeder und Herrn Ott:
Aleyna Akbulut, Nilay Aydemir, Elias Beer, Julian Borchers, Luana castro, Muna Das, Raffaela di Motoli, Konstantin Erhart, Matilda Franzkowiak, Sofie Golka, Alexander Heering, Maja Herzog, Jona Kasper, Selin Kayhan, Lukas Keßler, Ceyhun Kiran, Leonie Könnecke, Johanna Krauthäuser, Nico Letter, Ben Lurz, Antonina Natrup, Max Nockemann, John Pick-Laaser, Aaron Posdziech, Nick Splettstößer, Emil Thönes, Marlon Wicher, Jaydeen Wietek, Laurenz Wollmann, Benjamin Zander.








Auszeichnung der Gesamtschule Heiligenhaus als „Digitale Schule“
Erneut unter den Besten: Die Gesamtschule Heiligenhaus wurde am 05. September 2024 in Paderborn für ihre Vorreiterrolle im Bereich der digitalen Bildung mit dem Siegel „Digitale Schule“ ausgezeichnet.
Diese Ehrung würdigt Schulen, die sich in besonderem Maße für die Vermittlung digitaler Kompetenzen einsetzen. Die Gesamtschule Heiligenhaus gehört damit zu den 107 Schulen in Nordrhein-Westfalen, die den Titel „Digitale Schule“ erhielten.
Mit dieser Auszeichnung wird das Bestreben der Gesamtschule Heiligenhaus gewürdigt, eine zeitgemäße Bildung zu bieten und Schülerinnen und Schüler auf die Herausforderungen der digitalen Welt vorzubereiten.
„Wir sind sehr stolz auf die Anerkennung unserer Arbeit in den Bereichen Digitalisierung, die Auszeichnung motiviert uns, unsere Schülerinnen und Schüler auch weiterhin auf die Herausforderungen der Zukunft vorzubereiten.“, so die Digitalisierungsbeauftragte Kathrin Oligmüller nach der Verleihung des Siegels.
Digitalisierung als strategischer Schwerpunkt
Die Gesamtschule Heiligenhaus wurde erstmals im Jahr 2021 ausgezeichnet. Seitdem arbeitet sie gezielt an der Weiterentwicklung ihrer digitalen Infrastruktur.
Bei der Bewerbung galt es, in einem Bewerbungsverfahren in fünf Kriterien zu überzeugen:
- Pädagogik & Lernkulturen 2. Qualifizierung der Lehrkräfte 3. Regionale Vernetzung 4. Konzept und Verstetigung 5. Technik und Ausstattung.
Als einen zentralen Baustein des Erfolgs der Gesamtschule Heiligenhaus sieht die Schulleiterin Carmen Tiemann die kontinuierliche Qualifizierung der Lehrkräfte. Durch Fort- und Weiterbildungen und die Einführung einer Arbeitsgruppe „Digitale Tools“ gelingt es, die Lehrkräfte in der Anwendung digitaler Technologien und digitaler Werkzeuge zu schulen und diese in den Unterricht zu integrieren.
Auch im Bereich der Ausstattung verfügt die Gesamtschule Heiligenhaus über eine moderne technische Ausstattung: In allen Klassenräumen sind ActivePanels installiert, und mobile iPad-Stationen ermöglichen digitale Unterrichtsformen. Hinzu kommen neue kreative Arbeitsmöglichkeiten im eigens eingerichteten LAB/Maker-Space, der sich besonders für Projektarbeiten wie Ton- und Videoaufnahmen eignet.
Neben der Vermittlung digitaler Kompetenzen hat die Schule seit 2022 den „Digitalen Tag“ in der Sekundarstufe II fest verankert. An diesem Tag arbeiten die Schülerinnen und Schüler von zu Hause aus, wobei der Unterricht vollständig digital stattfindet. Diese Form des digitalen Lernens hat sich in Evaluationsrunden als effektiv erwiesen und wird von Schülerinnen und Schülern, sowie Lehrkräften gleichermaßen geschätzt.
8. Gentechniktag 2025
vom 13.02.2025 bis zum 14.02.2025 fanden bei bereits zum 8. Mal die „Gentechnik-Tage “ statt.
Schülerinnen und Schüler der Biologie Leistungs- und Grundkurse der Jahrgangsstufe Q2 erhielten an diesen Projekttagen vertiefende Einblicke in die Anwendung moderner gentechnischer Methoden und führten selbständig Experimente zur „Analyse von DNA“ und zur „Genklonierung“ unter Anleitung der Fachlehrer durch.
Schwerpunktmäßig ging es dabei um die Herstellung gentechnisch veränderter Bakterien mittels Transformationsversuchen durch.
Diese gentechnischen Methoden werden heutzutage verwendet, um Arzneimittel wie Insulin oder gentechnisch veränderte Lebensmittel herzustellen.




































































































Als “MINT freundliche Schule“ ist es unser Ziel, einen qualitativ hochwertigen Unterricht mit vielen praktischen Bezügen anbieten zu können, der zusätzlich optimal auf die Anforderungen des Abiturs vorbereitet.
Wir sind sehr stolz, dass wir es schaffen, dieses aufwändige und teure Projekt in Eigenregie unter Aufwendung von Mitteln des Fördervereins der Schule durchführen zu können.

Wir sind erneut fobizz Schule!
Wir freuen uns sehr, mitteilen zu können, dass unsere Schule zum wiederholten Male als fobizz Schule ausgezeichnet wurde. Diese Anerkennung erhalten wir für unseren herausragenden Einsatz im Bereich der digitalen Bildung.
Unser Kollegium bildet sich regelmäßig im Bereich digitale Kompetenzen fort, um unseren Schülerinnen und Schülern die bestmögliche Bildung zu bieten. Wir sind stolz darauf, dass unser Engagement und unsere kontinuierliche Weiterbildung erneut gewürdigt wurden.
Ein herzliches Dankeschön an unser gesamtes Team für ihren unermüdlichen Einsatz und an fobizz für diese wertvolle Auszeichnung.

GEH Weihnachtssong 2024
Von dem letztjährigen Weihnachtssong haben sich zwei Schüler des damals 10. Jahrgangs inspirieren lassen und eine Techno-Variante entwickelt. Die Kreativität und das Engagement der Schüler hat überzeugt, so dass der diesjährige Song bereits im April fertig war. Die fehlenden Bilder für das Video hat der DG-Kurs im Jahrgang 9 unter der Leitung von Frau Gehmeyr entwickelt. So wurde der bekannte Text mit neuem Sound und aktuellen Bildern zu unserem Weihnachtssong 2024: „Zeit des Lichts 2“.
Besonder hinweisen möchten wir Sie noch auf unseren digitalen Adventskalender, der am 07.12.24 freigeschaltet wird.
Wir wünschen allen eine friedliche Adventszeit!
Impressionen vom Tag der offenen Tür 2024 und der diesjährigen Weihnachtstütenaktion

















































Besuch der Invictus Games ’23


Gentechniktag ’23


Gentechniktag ’23

Gentechniktag ’23


Skifahrt ’24


Skifahrt ’24


Skifahrt ’24


Skifahrt ’24


Skifahrt ’24


Skifahrt ’24


Skifahrt ’24


Projekt „Stratosphärenballon „


Projekt „Stratosphärenballon „


Projekt „Stratosphärenballon „




Sponsorenlauf ’23


Projektwoche ’23 „Gesundheit“


Projektwoche ’23 „Gesundheit“


Projekt „Stratosphärenballon“ ’23

Projekt „Stratosphärenballon“ ’23

Gentechniktag ’23

Gentechniktag ’23

Gentechniktag ’23

Skifahrt ’24

Skifahrt ’24

Skifahrt ’24

Skifahrt ’24

Skifahrt ’24

Skifahrt ’24

Skifahrt ’24

Besuch der Invictus Games ’23


Sponsorenlauf ’23

Medienscouts ’23

Projektwoche ’24 „Gesundheit“

Projektwoche ’24 „Gesundheit“
Kontakt
-
Telefon
<p>02056-60227</p> -
Adresse
<p>Hülsbecker Str. 5, 42579 Heilgenhaus</p> -
Email
<p>info@gesamtschule-heiligenhaus.de</p>


